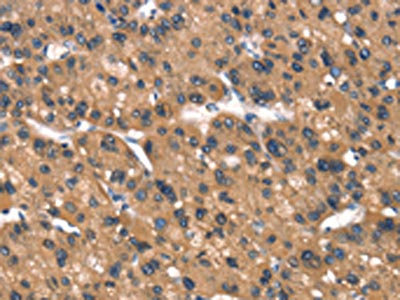

DAAM1 Antibody
-
中文名稱:DAAM1兔多克隆抗體
-
貨號:CSB-PA135938
-
規格:¥1100
-
圖片:
-
The image on the left is immunohistochemistry of paraffin-embedded Human liver cancer tissue using CSB-PA135938(DAAM1 Antibody) at dilution 1/40, on the right is treated with synthetic peptide. (Original magnification: ×200)
-
The image on the left is immunohistochemistry of paraffin-embedded Human gastric cancer tissue using CSB-PA135938(DAAM1 Antibody) at dilution 1/40, on the right is treated with synthetic peptide. (Original magnification: ×200)
-
Gel: 6%SDS-PAGE, Lysate: 40 μg, Lane 1-2: Hela cells, 293T cells, Primary antibody: CSB-PA135938(DAAM1 Antibody) at dilution 1/350, Secondary antibody: Goat anti rabbit IgG at 1/8000 dilution, Exposure time: 1 minute
-
-
其他:
產品詳情
-
Uniprot No.:
-
基因名:
-
別名:DAAM1 antibody; KIAA0666 antibody; Disheveled-associated activator of morphogenesis 1 antibody
-
宿主:Rabbit
-
反應種屬:Human,Mouse
-
免疫原:Synthetic peptide of Human DAAM1
-
免疫原種屬:Homo sapiens (Human)
-
標記方式:Non-conjugated
-
抗體亞型:IgG
-
純化方式:Antigen affinity purification
-
濃度:It differs from different batches. Please contact us to confirm it.
-
保存緩沖液:-20°C, pH7.4 PBS, 0.05% NaN3, 40% Glycerol
-
產品提供形式:Liquid
-
應用范圍:ELISA,WB,IHC
-
推薦稀釋比:
Application Recommended Dilution ELISA 1:1000-1:2000 WB 1:200-1:1000 IHC 1:50-1:200 -
Protocols:
-
儲存條件:Upon receipt, store at -20°C or -80°C. Avoid repeated freeze.
-
貨期:Basically, we can dispatch the products out in 1-3 working days after receiving your orders. Delivery time maybe differs from different purchasing way or location, please kindly consult your local distributors for specific delivery time.
-
用途:For Research Use Only. Not for use in diagnostic or therapeutic procedures.
相關產品
靶點詳情
-
功能:Binds to disheveled (Dvl) and Rho, and mediates Wnt-induced Dvl-Rho complex formation. May play a role as a scaffolding protein to recruit Rho-GDP and Rho-GEF, thereby enhancing Rho-GTP formation. Can direct nucleation and elongation of new actin filaments. Involved in building functional cilia. Involved in the organization of the subapical actin network in multiciliated epithelial cells. Together with DAAM2, required for myocardial maturation and sarcomere assembly.
-
基因功能參考文獻:
- coiling phagocytosis is a mechanism for borrelial internalization by neuroglial cells mediated by Daam1 PMID: 29746581
- Results provide evidence that Daam1 activates RhoA to regulate Wnt5ainduced glioblastoma cell invasion. PMID: 29207169
- DAAM1 organizes actin filaments into a nodal complex PMID: 27760153
- Kank1 plays a crucial role in regulating the activity of RhoA through retrieving excess Daam1 and balancing the activities of RhoA and its effectors. PMID: 28284839
- High Daam-1 expression may upregulate the Wnt/PCP pathway and cause idiopathic pulmonary arterial hypertension PMID: 28288669
- Kif26b, together with Dvl3/Daam1, initiates cell polarity through the control of planar cell polarity-signaling pathway-dependent activation in endothelial cells. PMID: 26792835
- Daam1 plays a dual role in the phagocytic uptake of borreliae. PMID: 24696301
- A developmentally restricted function of miR-490 and its putative DAAM1 target are associated with exaggerated megakaryocytopoiesis and/or proplatelet formation. PMID: 22869791
- Wnt5a promotes breast cancer cell migration via Dvl2/Daam1/RhoA. PMID: 22655072
- DAAM1 is a formin required for centrosome re-orientation during cell migration. PMID: 20927366
- Fli-I promotes the GTP-bound active Rho-mediated relief of the autoinhibition of Daam1 and mDia1. Thus, Fli-I is a novel positive regulator of Rho-induced linear actin assembly mediated by DRFs. PMID: 20223827
- DAAM1 regulates endothelial cell growth through MT stabilization in a cell type-selective manner PMID: 20351293
- DAAM1 was shown to bind to the SH3 domain of CIP4 in vivo. PMID: 16630611
- Results report that Profilin1 is an effector downstream of Daam1 required for cytoskeletal changes during gastrulation. PMID: 17021034
- The DAAM1 FH2 domain structure, determined at 2.25 A resolution, and DAAM1 actin binding activity PMID: 17482208
- Crystal structure of human DAAM1 formin homology 2 domain PMID: 17986009
- a carboxyl-terminal binding partner, Dvl, has a role in activation of Daam1 PMID: 18162551
- mDia1 and Daam1 are platelet actin assembly factors having distinct efficiencies, and they are directly regulated by Rho GTPases PMID: 18218625
顯示更多
收起更多
-
亞細胞定位:Cytoplasm. Cytoplasm, cytoskeleton, cilium basal body. Note=Perinuclear.
-
蛋白家族:Formin homology family
-
組織特異性:Expressed in all tissues examined.
-
數據庫鏈接:
Most popular with customers
-
-
YWHAB Recombinant Monoclonal Antibody
Applications: ELISA, WB, IHC, IF, FC
Species Reactivity: Human, Mouse, Rat
-
Phospho-YAP1 (S127) Recombinant Monoclonal Antibody
Applications: ELISA, WB, IHC
Species Reactivity: Human
-
-
-
-
-